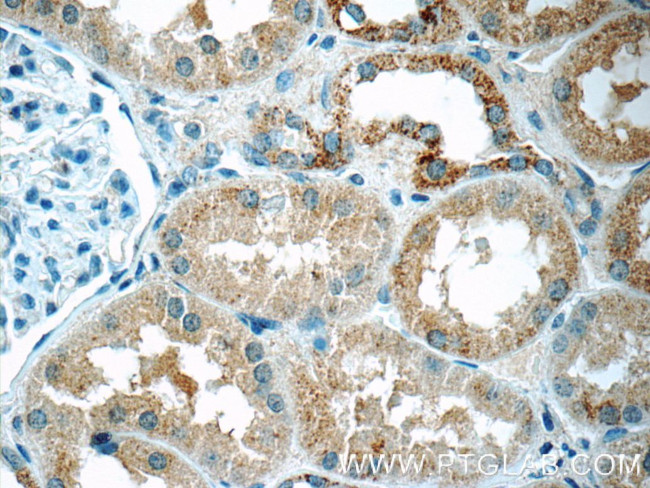
DTX3 Antibody in Immunohistochemistry (Paraffin) (IHC (P))
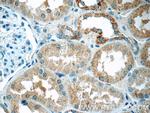
DTX3 Antibody in Immunohistochemistry (Paraffin) (IHC (P))

Search
Proteintech
DTX3 Polyclonal Antibody
{{$productOrderCtrl.translations['antibody.pdp.commerceCard.promotion.promotions']}}
{{$productOrderCtrl.translations['antibody.pdp.commerceCard.promotion.viewpromo']}}
{{$productOrderCtrl.translations['antibody.pdp.commerceCard.promotion.promocode']}}: {{promo.promoCode}} {{promo.promoTitle}} {{promo.promoDescription}}. {{$productOrderCtrl.translations['antibody.pdp.commerceCard.promotion.learnmore']}}
产品信息
25304-1-AP
种属反应
宿主/亚型
分类
类型
抗原
偶联物
形式
浓度
规格
纯化类型
保存液
内含物
保存条件
运输条件
产品详细信息
Immunogen sequence: MSFVLSRMA ACGGTCKNKV TVSKPVWDFL SKETPARLAR LREEHRVSIL IDGETSDIYV LQLSPQGPPP APPNGLYLAR KALKGLLKEA EKELKKAQRQ GELMGCLALG GGGEHPEMHR AGPPPLRAAP LLPPGARGLP PPPPPLPPPL PPRLREEAEE QESTCPICLG EIQNAKTLEK CRHSFCEGCI TRALQVKKAC PMCGRFYGQL VGNQPQNGRM LVSKDATLLL PSYEKYGTIV IQYVFPPGVQ (1-249 aa encoded by BC114498)
靶标信息
Regulator of Notch signaling, a signaling pathway involved in cell-cell communications that regulates a broad spectrum of cell-fate determinations. Probably acts both as a positive and negative regulator of Notch, depending on the developmental and cell context. Functions as an ubiquitin ligase protein in vitro, suggesting that it may regulate the Notch pathway via some ubiquitin ligase activity.
仅用于科研。不用于诊断过程。未经明确授权不得转售。
生物信息学
蛋白别名: deltex 3, E3 ubiquitin ligase; deltex homolog 3; Deltex3; E3 ubiquitin-protein ligase DTX3; FLJ34766; mDTX3; MGC138863; MGC138864; probable E3 ubiquitin-protein ligase DTX3; Protein deltex-3; putative E-3 ligase; RING finger protein 154; RING-type E3 ubiquitin transferase DTX3; unnamed protein product
基因别名: Deltex3; DTX3; mg310; RNF154
UniProt ID: (Human) Q8N9I9, (Mouse) Q80V91
Entrez Gene ID: (Human) 196403, (Mouse) 80904